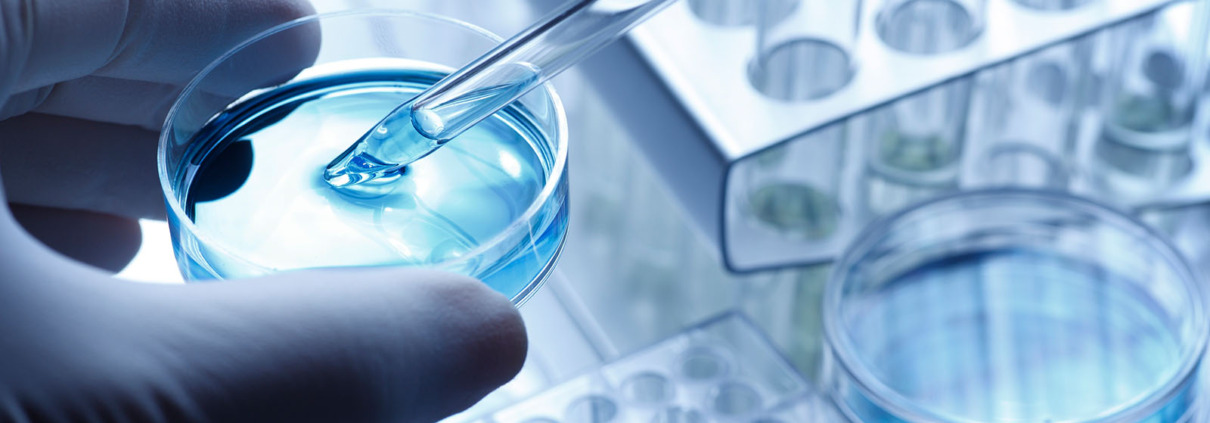
Klinik Donaustadt testet Nierenkrebs-Impfung

Klinik Donaustadt testet Nierenkrebs-Impfung
Weniger Nebenwirkungen und geringerer Aufwand durch neue Therapie
Krebstherapien entwickeln sich stetig weiter. Der Fokus: eine höhere Lebensqualität und eine möglichst geringe Belastung durch die Behandlung. So könnte es bei Nierenkrebs bald einen therapeutischen Impfstoff geben. Einige Patient*innen haben nach der operativen Entfernung des Nierentumors ein hohes Risiko, dass der Krebs wiederkommt. Aktuell werden dagegen Medikamente eingesetzt, die sehr starke Nebenwirkungen haben können, z.B. Schilddrüsenunterfunktionen. Teilweise sind diese sogar irreversibel und die Patient*innen müssen lebenslang Medikamente nehmen. Daher wird nun an einer nebenwirkungsarmen Therapie geforscht, bei der maximal klassische Begleiterscheinungen einer Impfung, wie Schwellungen der Einstichstelle, auftreten können.
Große internationale Studie mit rund 400 Patient*innen
Ende des Jahres startet dazu in der Klinik Donaustadt eine Studie. Untersucht wird der Impfstoff eines Schweizer Pharmaunternehmens. „Es handelt sich dabei um eine Immuntherapie aus körpereigenem Tumormaterial. Dass dieser Ansatz grundsätzlich funktioniert, konnte bereits gezeigt werden“, erklärt Martin Marszalek, Leiter der Abteilung für Urologie und Andrologie der Klinik Donaustadt. Und ergänzt: „Wir sind stolz darauf, dass wir in der Klinik Donaustadt Krebs-Patient*innen auf höchstem Niveau versorgen und zugleich in der Forschung sowie der Entwicklung neuer Therapien eine wichtige Rolle spielen.“ Auch andere Spitäler im In- und Ausland nehmen an der Studie teil. Insgesamt werden rund 400 Patient*innen untersucht. Erste Zwischenergebnisse erwartet der Facharzt für Urologie und Andrologie nach rund einem Jahr.
Weniger Aufwand für Patient*innen bei Verabreichung
Ein weiterer Vorteil wäre die einfache Anwendung. Während bei der medikamentösen Therapie über ein Jahr lang mehrstündige Infusionen nötig sind, würden wenige Impfgaben reichen. Da die Therapie individuell auf die jeweiligen Patient*innen zugeschnitten wird, sind die Kosten entsprechend hoch. Sollte der Impfstoff zugelassen werden, wird er vorrangig Hochrisiko-Patient*innen zur Verfügung stehen.
Organerhaltende Nierenkrebs-Entfernung dank Da Vinci-OP-Roboter
Die meisten Nierenkrebs-Patient*innen sind nach einer operativen Tumorentfernung geheilt. Dabei hat sich die Klinik Donaustadt auf Eingriffe mit dem Da Vinci-OP-Roboter spezialisiert. Patient*innen profitieren von besseren Ergebnissen durch höhere Präzision, weniger Schmerzen und einer schnelleren Genesung. „Jährlich machen wir bei Nierentumoren rund 120 Eingriffe mit roboterassistierter Chirurgie, die es uns ermöglicht, auch sehr komplexe Nierentumore organerhaltend zu operieren“, sagt Martin Marszalek.